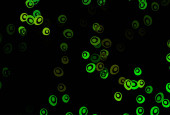
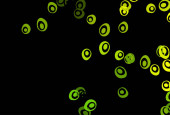

Ciemnozielony, żółty wzór wektora z okręgami.

Informacje o pliku:
| Numer pliku: | 0101410148314 |
| Typ pliku/format: | Wektory ( ZIP ) |
| Rozdzielczość: | 3333x2267 (28,22x19,19 cm 300 dpi) |
| Kategorie: | |
| Autor: | Best_Vector |
| Zalecany program: | Adobe Illustrator |